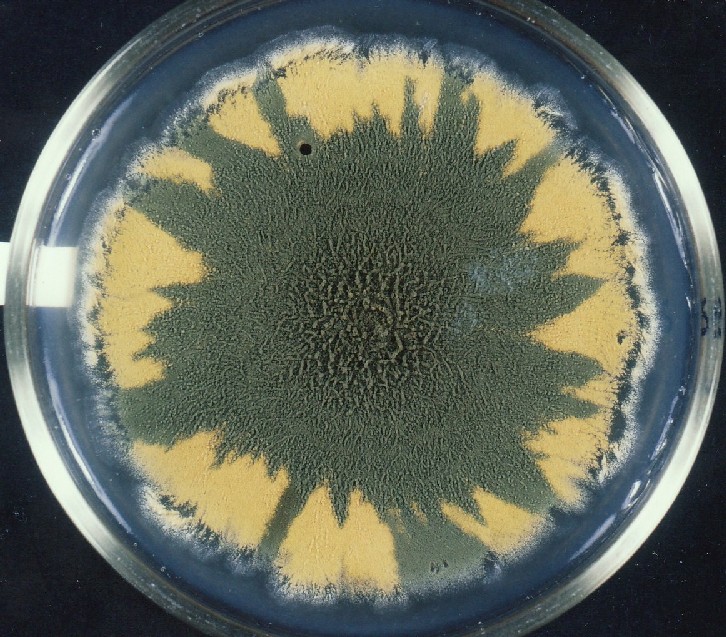

|

Plant Genomics &
Developmental Biology Consultant / Expert Offering Creative Paradigms
for Scientific Advancement in Agriculture and Medicine, with Emphasis on
Plant Genetics / Genetic Engineering and Developmental Biology, e.g.,
Organogenesis.
Michael
M. Lieber, Ph.D. Berkeley, CA (510)
526-4224
Adaptively Responsive Mutation on the Karyotypic Level Manifested as
Pattern Differentiation and Morphogenesis in a Fungus: Further Steps
into a New Paradigm, with Implications for Agriculture
I. Introduction: Environmentally Responsive Mutagenesis on Different
Levels of the Genome
Environmentally
Responsive Mutation on the Molecular/Gene Level
Relatively recent investigations of mutations generated in various
unicellular or simple, undifferentiated colonial organisms have revealed
what can be considered as the beginnings of a paradigm shift in biology.
During the past 27 years, adaptively responsive, enhanced mutation has
been found in bacteria and yeast, and in 1969, evident within the
unicellular green alga, Chlamydomonas, an eukaryote. Though in the case
of yeast, there was also a far earlier report (Lindegren, 1966) of
adaptively responsive mutation. Such enhanced mutations, linked to
stress, enabled the quick adaptation of the single cells of the organism
to changed, stressful situations. In some studies, such adaptation to a
particular nutritional stress enabled single cells in non-growing
bacterial colonies to produce adapted, growing clones or sectors, called
papillae. While in many other studies involving other types of
nutritional stress, such adaptation enabled the growth of whole colonies
from single cells during the stressful conditions. In 1989, 1990,
1998, and 2000,
as well as
in 2001, the author showed, through his own work on bacteria under
nutritional stress, that the occurrence of adaptively responsive
mutations resulting in growing colonies is under internal, genetic
control or regulation, hence non-random, demonstrating developmental
features. As pointed out, this suggested the evolution of an inner, mutator capacity that could have modulated evolution itself. Earlier
in
1967, it was also pointed out by the author that the enhanced occurrence
of many types of mutation was non-random, being under genetic regulation
through internal mutator processes, whose existence in the past could
have enhanced the degree of evolution from within. (Also, see references
in Lieber, 2011 and references via http://www.googlescholar.com. )
The non-randomness of enhanced mutations, occurring within organisms
under non-lethal stress, has become clearly manifested repeatedly in the
last 27 years of mutation research. However, during this 27-year period
of investigations, the particular, non-random mutations studied were
only adaptively responsive mutations to nutritional requirements and to
the stress of antibiotics. And, in the case of the green alga, the
adaptively responsive, frequent mutations occurring on the culture
medium enabled growth of many colonies of joined cells in the presence
of a growth inhibitor in the culture medium, another type of chemical
stress. These adaptively responsive, enhanced mutations enabled
adaptation to stress on the biochemical or molecular level of
organization in unicellular organisms, as opposed to higher levels of
organization, such as on the level of morphogenesis in a multicellular,
differentiated organism, relatively far more complex than bacteria
colonies and the colonial algae.
(Also,
see Addendum I.)
Environmentally Responsive Mutations on the
Karyotypic Level
In unique contrast, very frequent mutations at the chromosomal level
due to or in response to physical stress can occur under inner control
that lead to adaptive changes in differentiation of pattern and
morphology in olive-green, multicellular fungal colonies having a
central, crinkled morphology, sparsely populated with
conidiophores/conidia, and of reduced linear growth rate at high temperature.
(See Lieber, 1998 for a description and earlier, relevant references.
View
PDF of Article.)
An environmentally responsive, innerly-controlled, greatly enhanced
mutation, through an environmentally responsive, complex, dual mutator, on a
higher genomic level determining development, was shown to exist many
years previously to most of the mutation studies referred to above, with
significant implications for evolution. (Investigations, observations and evidence
are described in Lieber, 1972, 1976b. Some of these observations and
related evidence is summarized in Addendum II.)
Investigation with the multicellular, differentiated eukaryotic fungus,
Asperillus nidulans, an ascomycete, once considered a lower plant,
revealed that very frequent mutations on the karyotypical or chromosomal
level of organization were an adaptive response to high temperature
stress. These environmentally responsive, adaptive, karyotypic mutations
resulted in the production of many yellow sectors in each sparsely
conidiated, olive-green colony. The sectors were composed of yellow,
a-sexual reproductive structures, the conidiophores made up of yellow
conidia-spores, the means of a-sexual production. The ensuing, enhanced
production of such mutant sectors manifested itself phenotypically in
response to a higher temperature level as a new type of
pattern-differentiation through such sectors and morphological change
within fungal colonies (Lieber, 1972, 1976b, 1998.)
Criteria for
Adaptive Features:
Such a new pattern of differentiation and change in morphology, based
on inner-controlled though environmentally responsive genomic changes, a
responsive, inner-controlled hypermutation, were adaptive in the
following ways to temperature stress: These genomic changes enabled,
under temperature stress, major increases in the production of yellow
a-sexual spores within differentiated, mutant yellow sectors. Such
genomic changes also enabled the greatly increased linear growth rate of such,
yellow sectors and their normal, flat morphology. Such spores are
necessary for a-sexual inheritance, and their flat, high growth-rate
morphology is characteristic of Aspergillii surviving well in various
environmental niches. In other words, "the improved morphology,
linear
growth-rate, and conidial production of such sectors would now suggest
[and reflect] an adaptively responsive, inner-directed mutagenesis to
temperature stress." (Lieber, 1998) This new pattern of
differentiation on the phenotypic level would be an expression of such
beneficial, enhanced responsiveness to physical stress through environmentally
responsive mutation. (To view colonies displaying such differentiation,
the reader is
directed to the photographs
at the end of this article. Also, go to
Figure 8.). This mutator system is in itself an example of a
developmental system capable of further evolution through its own
inner-controlled, adaptively, responsive, enhanced mutability at the karyotypic
level.
II. Details of the Investigation with Aspergillus nidulans, a
Plant-Like Organism
The fungus investigated, Aspergillus nidilans, is a normally haploid,
eukaryotic ascomycete with eight chromosomes. Its colonies have
internally septate hyphae made up of multinucleated cells divided by the
septae. Without chromosomal re-arrangements or new chromosomal
configurations within the haploid genome, the fungus produces flat,
grass green colonies due to green conidiophores emerging vertically from
multinucleated hyphae composing the colonies. The colonies display high
growth rates at various temperatures (Lieber, 1972, 1976a.). Colonies
with a single, new chromosomal configuration in each of their haploid
nuclei have a crinkled morphology and a reduced linear growth rate, especially
at high temperature. One new chromosomal configuration, a uni-mutator, responds mutagenically
to various temperatures, ensuing in colonies producing, at various mean-frequencies, yellow mutant sectors with improved,
linear growth
rates (Lieber, 1976a.) Colonies of this genotype were used as controls
in the investigations described below. This fungus produces a-sexually
reproductive spores. Each spore, a conidium, has a single nucleus.
Other strains of Aspergillus nidulans investigated at various temperatures had two chromosomal, non-uniform configurations in the
haploid genome. These configurations have respectively partial
duplications in trans of chromosomes I (Dp I) and III (Dp III), the
latter of various sizes. (Dp I and Dp III
were carried on respective chromosomal translocations.) Aspergillus
colonies with these two configurations in the haploid genome are much
smaller than normal colonies. They display a crinkled morphology,
especially pronounced at high temperature, and produce far less
vegetative spores or conidia at higher temperature, e.g. 39.5 degrees
centigrade (Lieber, 1972, 1976b.) One of these configurations, referred
to as Dp I, contains two genes for conidial or conidiophore color, one
green and one for yellow. The two color alleles are heterozygous within
the duplication, the green allele being dominant to the yellow allele, hence the green or
olive-green color of the colonies, that is colonies having green or
olive-green conidia and conidiophores within the crinkled area. In some
nuclei, a specific region of Dp I containing the green allele is subject
to deletions, resulting in yellow sectors of increased linear growth rate.
As
earlier investigations have documented with evidence, the frequency of
such deletion, and of corresponding yellow-sector production, is
influenced greatly by the other duplication, Dp III after it becomes
reduced in size and by temperature. Dp
III of reduced size responsively controls the degree of specific deletions from Dp I (Lieber,
1972. 1976b). Dp III, before it is reduced due to deletions from it, also affects or enhances the
degree of deletions from Dp I, but to a far lesser extent than the reduced
III duplication. For example, the dual mutator strain with the reduced
Dp III, present from the start of colonial growth, produces far more
yellow mutant sectors per colony than colonies having the intact,
non-reduced Dp III present from the start of colonial growth. And this
difference in mutation frequencies is significantly different at P<
0.01. This clearly indicates that as Dp III becomes reduced in size due
to deletions, it can greatly enhance the degree of deletions from Dp I.
As Professor Charlotte Auerbach noted in a personal communication in
1975, " It seems that DpIII acts as a pacemaker for DpI, and that this
interaction becomes more pronounced as the process of reduction of DpIII
proceeds."
This also demonstrates that the very instability of this mutator system can lead to
its greatly enhanced mutator effects through the pacemaker.
Description and Involvement of the Responsive, Karyotypic Dual Mutator
Modulated by temperature and the age of the conidia from which colonies
are obtained, Dp III, depending on its size, controls the degree, timing and pattern of deletion
including the green allele on Dp I within colony genomes. (Lieber, 1972,
1976b). After Dp III becomes reduced in size as a result of deletions
having occurred from it, the reduced Dp III enhances the deletion of the
genetic region including the green-allele region of Dp I within colony
genomes. (Genetic analysis confirmed the occurrence of such deletions.) A deleted segment, a type of transposition element from Dp III,
probably inserted near the green allele on Dp I, may have induced under the
control of the reduced Dp III such deletion. It was proposed that induced
heterochromatization by Dp III within a region of Dp I, containing the inserted element, was
involved. When this occurs under a temperature
stress, that is, at a high temperature opposed to a lower temperature, this mutagenic, deletional
interaction of the two configurations, via a likely transposition
process, is enhanced to an even a far greater degree in colonies having
a particular culture history.
Moreover, this
mutagenic enhancement is clearly regulated, since the improved, yellow
sectors, as a consequence of the deletions from Dp I in many nuclei, all
emerge at the same time during colonial growth. Furthermore, this
temporal control of deletion, clearly under the control of the reduced
Dp III, becomes far more pronounced or effective at the stressful,
higher temperature. (Evidence presented in Lieber, 1972, 1976b.). This
would be a controlled hyper-mutagenesis responding or tuned to a temperature
stress. This would be through a environmentally responsive, two-part mutator system on the karyotypic level. The severe dampening, epigenetic
influence of age-affected conidia on the degree of mutagenetic
interaction, in cultures obtained from these conidia, is also suppressed
epigenetically through this higher temperature [Lieber, 1972].
Specifically, at that higher temperature, irrespective of the age-state
(or epigenetic state) of the conidia producing the fungal colonies, the
adaptive consequences of this very frequent, deletional mutagenesis or
instability, possibly during mitosis, on the karyotypic level of
organization, are fungal colonies that each symmetrically produce many
yellow sectors of increased linear growth rate, with abundance of conidia or
conidiophores, and of a relatively smooth or non-crinkled morphology.
Such are consequences that are very much adaptive to the new temperature
situation or stress, especially in the long-term, from the standpoint of
the evolution of new adaptive strains of Aspergillus in terms of new
differentiation patterns. Moreover, the configurationally, partial
duplications, controlling such adaptation, are in effect an adaptively
responsive, complex, two-part mutator system on the chromosomal or
karyotypic level, and a system which exhibits internal regulation,
though environmentally sensitive or responsive, and one whose mutagenic
behavior is a-sexually inheritable via conidia and sexually
transmittable to a F1 generation via ascospores (Lieber, 1972, 1976b.)
As can be seen, this dual mutator system derives from genomic
re-organizations on the karyotypic level. Many types of mutator systems,
environmentally sensitive, derive from past genetic re-organizations (Lieber,
1972, 1976b).
Karyotypic Dual Mutator Responds to Stress with
Beneficial, Phenotypic Effects
This situation with Aspergillus indicates that inner-controlled,
internally-regulated, very frequent karyotypic change can nevertheless
be induced or influenced by a physical stress, namely high temperature,
in such a manner that such controlled karyotypic changes result in
adaptive changes on the differentiation/morphological, phenotypic level. This is shown as
being manifested by the greatly increased production of a-sexual
spores, increased linear growth rate, and a flat morphology characteristic of
well adapted Aspergilli in diverse regions. This would be an example of a karyotypic-based,
adaptively responsive differentiation/morphological change responding to a physical stress,
a situation that has not been demonstrated before. This is highly
significant as it now demonstrates that morphological and
differentiation patterns can be adaptively responsive to stress through
a stress-induced or modulated mutagenesis involving genomic
configurations. These are in effect developmental, controlling elements
on the karyotypic level, apparently regulating the excision and insertion
of smaller transposition elements within the configurations.
The physical stress influences, possibly via cytoplasmic changes and related nuclear-membrane
distortions, the inner-controlled mutagenic interaction of the genomic
configurations, in such a way, that control becomes enhanced leading
responsively (within one generation) to very frequent, karyotypic-based, controlled changes
in differentiation and morphogenesis in fungal colonies. As well as involving the controlled
insertion and release of small heterochromatic controlling-elements through controlled
intrachromosomal recombination, the stress-related
mechanism of such control could also involve controlled inaccessibility of genomic regions
to possible nuclear-membrane replication sites and consequent controlled deletion of genomic
regions, where cytoplasmic induced heterochromization
could play a role in the accessibility (Lieber, 1976b).
Such responsive enhancement on the karyotypic level enables in
some manner, communicated dynamically through different levels of organization,
effective adaptive changes on the phenotypic level, that is, on the organismal level. The resulting karytotypic alterations or variations
have become co-extensive with the many yellow mutant-sectors within each
of a large number olive green colonies, and thereby, coextensive with a
new, adaptive pattern of differentiation and morphogenesis. This is in
effect a responsively induced, new karyotypic analogue of an adaptive
differentiation and morphogenesis within a short period. It would be
important to know the relationship-translation between karyotypic
changes at one level and those adaptive, phenotypic changes at a higher
level. Interestingly, from the perspective or level of population
genetics, this
coextensive karyotypic variation with phenotypic variation on one scale would also be like an induced,
phenotype/genetic
variation within a population on a macro-scale.
III. An Adaptive Phenomenon Apparently Unique in the History of Such
Investigations
In the history of investigations into adaptively or environmentally
responsive mutagenesis, the adaptive phenomenon involving Aspergillus
was not previously observed. This was especially the process whereby controlled,
very frequent karyotypic change under and through physical stress can be
manifested adaptively in a short period, as very frequent, adaptive
changes in morphology, growth, and patterns of differentiation within
growing, multicellular fungal colonies under stress. It is appreciated,
however, that such responsive adaptation via karyotypic-mutator systems,
whether or not transposition elements are involved, may not be perfect,
as some karyotypic changes could be deleterious. Nevertheless, the type
of environmentally responsive mutator systems within Aspergillus could
have themselves evolved into more effective mutator systems, with
developmental features. Such features would have lead to more effectively adaptive
developmental or morphological solutions to various types of
environmental and internally-related epigenetic stress.
In the laboratory, a small
number of genetic crosses involving the hybridization of different karyotypes of Aspergillus
resulted in the production of the karyotype-based mutator system. Analogously, during
evolution, such repeated hybridizations within very short periods could have ensued in
many organisms having environmentally responsive karyotypic mutator systems affecting
differentiation and morphogenesis, and thereby their inner evolution. In this manner, many adaptive changes in the developments
of organisms could have been generated repeatedly in very short periods during their
evolution.
Phenotypic Effects of Karyotypic Mutator Similar
to Genetic Assimilation
This phenomenon brings to mind the phenomenon of the genetic
assimilation of induced morphological or phenotypic changes involving stress in
Drosophila, first discovered and investigated by C. H. Waddington in the
1950s (Waddington, 1953, 1956a, & 1959.) For example, when developing
Drosophila embryos are subject to ether vapor stress-treatments or
shocks during a certain period in their development, a portion of the
Drosophila develop two thoraxes with two pairs of wings in adult flies.
During each fly generation exposed to ether stress, developed bithorax
flies were inbreed or crossed. When after a relatively small number of
generations of such inbreeding under stress, a very large proportion of
the subsequent progeny resulting from repeated inbreeding for the new
morphology, when not subject to ether vapor shocks during embryogenesis,
still developed the bithorax phenotype as adults.
In response to stress,
the new morphogenesis---and the changed pattern of regulatory processes
connectedly involved---have become genetically inheritable or
assimilated in a relatively short period in some manner. In other
experiments, where inbreeding also involved a relatively small number of
adult generations, other types of morphological changes, such as changes
in wing morphology, eye morphology and in anal excretory papillae, were
also inheritably assimilated or canalized when generations of their
developing embryos were subject to other types of imposed environmental
stresses, such as temperature shocks with regard to wing and eye
development and intense salt treatments of embryo food with regard to
papilla size.
Though it was not demonstrated that many of such responsive, genetically
based (or canalized), environmentally responsive morphological changes
were adaptive to the environmental stresses, the genetically assimilated
increase in papilla size as a response to salt stress may, however, have
allowed adaptation to the increased salinity in a relatively short
period and to any future increases, as Waddington pointed out. It was
not ascertained whether or not new mutations on the gene level were
induced through the imposed environmental stresses during embryogenesis,
though this possibility cannot be ruled out, and is worthy of further
investigations. (As will be described shortly, a subsequent investigation does in fact
suggest genetic changes being involved.) Also, these morphological changes might have enabled the
development of less obvious, internal adaptive features in a complementarity with the evident, canalized morphological changes. This
possibility would also be well worth investigating. In this connection,
see Lieber, 2011 regarding enabling mutations.
More recent, stress-involved assimilation-experiments were performed
with a black caterpillar species. Developing progeny of such were
subject to heat shocks within each developing, caterpillar generation.
As a consequence, green adults developed during each of 13 generations
subject to heat shock. Subsequently, developing caterpillars eventually
became inheritably green without heat shock after 13 generations through
repeated inbreeding of green progeny caterpillars that had developed in
each of those 13 generations (Suzuki and Nijhout, 2006.) As the authors
point out, it is feasible that such inheritably acquired color via heat
stress would be adaptive as an effective camouflage in a environment of
green, leafy vegetation during the warm season, and thus evolutionally
adaptive in a relatively very short period in the context of evolution.
It was Waddington who had pointed out the importance of genetic
assimilation in morphological and pattern evolution. Such developmental,
genetic assimilation of features at the organismal level during
evolution could have involved some types of genomic change on the
karyotypic level, which they and their effects could have become
repeatedly combined through a relatively short period of inbreeding,
thereby accounting for an adaptive assimilation during a relatively,
very short period, enabling an accelerated evolution. (Relevantly, the
adaptive, Aspergillus mutator-system was created through types of
inbreeding involving reorganized chromosomes.) Regarding such genetic or
inheritable assimilation of environmentally induced characters, a change
in genomic organization is clearly suggested (Piaget, 1974.)
In a more recent investigation
with Drosophila, the genetic assimilation of the cross veinless phenotype, through
heat shocks, was demonstrated again. In that investigation, chromatin changes ultimately led
to such genetic assimilation. It was suggested that chromosomal rearrangements in chromatin
modifier genes occurred. This ensued in position effect variegation via long range heterochromatization, and thereby gene silencing, of genes involved in wing development
(Nair and Dearden , 2016.) These findings suggest that chromatin changes could also have
played a role in various genetic assimilations of phenotypic changes due to environmental
stresses. Such
inheritable assimilation of environmentally-induced morphological and
regulatory changes, likely based on chromatin changes or rearrangements and less evident, enabled features, could have
contributed to the rapid evolution of developmental systems in various
organisms.
Possible
Role of Karyotypic Mutators in Genetic Assimilation:
The role of karyotypic mutators in this cannot be ruled out. This
becomes especially feasible in view of the following found with the
Aspergillus mutator system: one can generate, through an a-sexual
selection from an extremely high mutant-sector, colonial producer at
high temperature, a group of colonies with a significantly,
further-increased mean frequency of yellow, mutant sectors at high temperature (mean
frequency of 21.00 mutant sectors per colony) compared to the mean mutant-sector frequency of another group of
colonies at high temperature (mean frequency of 13.7 mutant sectors per colony) [Lieber, 1972].
Through recent analysis, these means are significantly different at P < 0.001. This would certainly
suggest a genetic assimilation of a further increased karyotypic mutator
effect at high temperature, possibly involving the stabilization of an
epigenetic change, itself stressful. And the high temperature stress
would be mutagenic in the context of the inner-mutator process. In a
way, this would be a non-linear, epigenetic extension of the mutator process.
Occurring in other situations, this could have affected the rate of
morphological evolution itself.
IV. The Evolution of Developmental Systems Due to Responsive Genomic
Changes
In this connection, a high, non-linear rate or burst of karyotypic
evolution has been correlated with a high, non-linear rate of
morphological evolution in mammals and in higher plants (Wilson et al.,
1977.) This may have involved karyotypic mutator systems similar to
those described in Aspergillus (Cherry et al., 1978). Furthermore, such
karyotypic mutator systems might even have been mutagenically responsive
to various environmental and internal pressures or stresses, such as
extremes in temperature and pre-mature aging. The consequences of such
might very well have been corresponding, nearly immediate morphological
changes that were adaptive to the new stresses. The inner-directed
changes or reorganizations on the karyotypic level of genetic
architecture could have resulted in corresponding, sudden
reorganizations of regulatory genetic networks, leading to the higher
level morphological changes. This may very well have accounted for the
high, non-linear rates of morphological evolution of the mammals and
higher plants. And there is some evidence that "morphological evolution
relies predominately on changes in the architecture of genetic
regulatory networks" (Prud'homme et al., 2007). Wilson et al. in
1977 also postulated the necessary involvement of genetic regulatory
regions in the morphological evolution of mammals and of higher plants.
Such changing architecture
would have to correspond to or composes the
dynamic architecture of morphogenesis, even though the avenues of this
will have to be defined. Again, the
problem is how different levels of organization dynamically interrelate
and integrate with one another. With regard to the Aspergillus mutator-system,
there is clearly a significant correspondence between inner-controlled karyotypic change at one level and adaptive phenotypic change at
another, involving differentiation and morphogenesis.
A karyotypic-regulatory, architectural basis for morphological
evolution, responsive to stress, appears to be reflected in plant evolution . Namely, frequent duplications of karyoptype,
leading to polyploidy and corresponding morphological changes during
plant evolution, have been shown to be associated with periods of
environmental stress (Vanneste et al., 2014.) Polyploidy in plants and
general karyotypic change have been very adaptive and have greatly
contributed to plant speciation. It cannot be ruled out that such
changes in ploidy or karyotype have had, or involved, a developmental,
mutator effect, determining in a controlled, specific, and refined
manner genomic changes on the karyotypic level. Such mutator systems
could have had their origin in those very karyoptypic re-organizations.
Relevantly, the creation of allotetraploids can create karyotypic
re-organizations that lead to or determine further genomic changes:
"Recent studies, mostly with plants, suggest that polyploidization can
induce a flurry of genetic and epigenetic events that include DNA
sequence elimination and gene silencing." (Pikaand, 2001). And following the
hybridization of two wheat species, an allopolyploid was created. In such, it was found that
"instantaneous genetic and epigenetic changes in the wheat genome [was] caused by
allopolyploidization" (M. Feldman and A. Levy, 2009).
Such
internally directed, further genomic change or re-organization could
also define the degree of evolution. In various plants and animals,
there are additional examples where there are subsequent karyotypic
changes, such as karotypic instabilities "in response to changes in
ploidy and interspecific hybridizations" (see Shaperio, 2011). The
existence of these processes in the past could have accelerated
morphological evolution. As long ago as 1940, the
geneticist, Richard Goldschmidt, argued that evolution, especially
macro-evolution, could have involved the responsive or directed
generation of mutation on the karyotypic/chromosomal level of
organization, ensuing in the sudden occurrence of organisms with new
developmental, primary patterns (Goldschmidt, 1940.)
Karyotypic
Mutator Systems Become Part of Developmental Systems While
Enhancing their Evolution: The Evolvability of Karyotypic Mutators
through Their Inner-Determined Mutations
Enhances the Evolution of Developmental systems
As also pointed out several years ago by the author, karyotypic mutator
systems may have contributed to and may have themselves become part of
the evolution of developmental systems in various organisms, and in so
doing, determining the very rate or degree of such an evolution (Lieber,
1972, 1975, 1976b, 1998.), thereby accelerating and enhancing the
evolution of
developmental systems. It is feasible in view of the adaptive Aspergillus system that such developmental systems would have been the
result of an adaptively or environmentally responsive and evolving
mutator system. Such an evolving system would have been due to its own
inner-controlled, responsive instability or hypermutation. This would be
its evolvability, which is a genetic-system's capacity to generate, new
adaptive variations on different levels of organization. A consequence of this
evolvability would
have been the evolution in various organisms of even more effective, mutator-based developmental systems.
Wherein, inner-controlled, minute karyotypic changes would have occurred as features of ontogeny. The
would constitute the enhanced evolvability of the evolution of adaptive
development.
Specifically, such an evolving and integrative mutator system, involving the
architecture of the karyotype, would have determined the very inner-evolvability
of the evolution of development in various organisms, including and
especially in higher plants. In effect, the responsively evolving
karyotypic-mutator-system would be the responsively evolving capacity to
evolve adaptive developmental systems, the inner-evolving evolvability of
evolution. Selection becomes synonymous with the increasing evolving
capacity for an increasing adaptive evolution; where, such evolving or
changing capability would have involved environmentally responsive, yet
inner directed, changing developmental
and responsive mutator systems on all levels across the succeeding
generations. Another avenue for evolution involving mutators
increasing from within the evolving capacity for adaptive evolution,
and hence implicit selection, might have
entailed a modern version of pangenesis, proposed by the author in 1967.
(See Mutation, Development and Evolution.)
V. Likely Consequences and Possibilities from the Evolution of
Karyotypic Mutator Systems
The Karyotpic,
Dual Hypermutator System is a Developmental
System Operating Through Responsive Temporal, Coordinate Control
Though originally occurring years ago, and first described in 1972, investigations of the
fungus, Aspergillus nidulans, have nevertheless explicitly revealed,
through further examination and interpretation (of earlier, referenced, published data), a
new type of environmentally responsive, adaptive mutation of high degree
on the karyotypic/chromosonal level, manifested phenotypically as
adaptive changes in growth, differentiation and morphology. This
phenomenon exhibited a temporal, coordinate, global, control through
Aspergillus colonies involving many nuclei in a common cytoplasm,
possibly mediated through the re-establishment of balanced forces within
the colonies. This would have been a control globally responsive to an environmental
stress. And such a responsive, global control would have enabled a quick, adaptive response to a
physical stress to and through the fungal colonies.
That is, the responsive, controlled, genomic-involved phenomenon occurs
within Aspergillus colonies when a flexible or plastic
accommodation to physical stress is necessary. By means of its timing
and coordination within Aspergillus colonies,
the global phenomenon is adaptively developmental through different levels of
organization, from karyotype to pattern differentiation and
morphogenesis on the level of the organism. Its coordination through
controlled temporality is a key adaptive feature of this responsive,
global phenomenon. This would be a coordination, a globalization, that
might have possibly involved, through periodic physiological and cytoplasmic changes in
growing colonies, global forces of a field achieving a stabilizing equilibrium or
uniformity of forces through different levels of organization of the fungus. Be this
as it may, the capacity to
generate this adaptively responsive phenomenon and the adaptive,
developmental consequences or features are themselves inheritable through sexual crosses
involving meiosis (Lieber,
1972, 1976b). See Figure 99 located
near the end of this article.
This phenomenon might also be indirectly related to other
environmentally responsive changes in development that have temporal,
coordinating features and that become inheritable, such as genetic assimilation. Such
genetic assimilation, through a type of developmental feed-back, could also define or
influence regulatory, cytoplasmic changes during development. In
effect, this karyotypic-mutator system is a responsive regulatory system, to its dynamic
internal milieu,
producing new karyotypic configuations and an associated hierarchy of
genetic and epigenetic regulatory changes that ensue in a new adaptive
morphology and pattern. There may be other, unknown types of
environmentally responsive mutator-systems yet to be discovered, which
have also played a significant role in the developmental evolution of
organisms. Nevertheless, it is likely that many developmental and
growth-pattern systems in plants and animals have evolved from a basic,
known developmental, karyotypic-mutator system, such as the one
discovered in Aspergillus. Such systems could also involve, refined, somatic
intra-chromosomal recombination. In fact, the process of deletion and
transposition in the Aspegillus mutator system was proposed to the scientific community as involving
specific, somatic intra-chromosomal recombination implicating
heterochromatin (Lieber, 1972, 1976b). Though not proposed at the time, such could occur
through a chromocenter. In various organisms, the heterochromatic regions, the centromeres, of the chromosomes
in a genome are joined together in a heterochromatic structure, referred to as a chromocenter,
though it is likely that such heterochromatin extends beyond the centromeres to some extent. Such a chromocenter
and the extended heterochromatin could provide an avenue for genetic exchange, via
recombination, between chromosomes during interphase. In various organisms, including higher
plants, such centromeres are composed of repetitive DNA and retro-transposons. Clustered
centromeres, the chromocenters, in certain fungi are in contact with the nuclear envelope
before mitosis. (See V. Yadav et. al., 2019 for updated research in this regard.) In
general, such contact or attachment to the nuclear membrane might stabilize the genetic
exchange via transposons. Other related mechanisms, involving proposed
nuclear-envelope replication-sites and heterochromatic regions, could also have played a
supplementary role in the inner-controlled mutagenesis (Lieber, 1976b).
Many Developmental
Systems May have Evolved from Karyotpic Mutators
In various invertebrate animals, controlled karyotypic changes, such as
deletions of heterochromatin, do occur within somatic cells as opposed
to germ cells, during development (Goday and Estaban, 2001; Beerman,
1966; Waddington, 1956b, p. 352). Such deletions or excisions may occur
through intra-chromosomal recombination (Beerman, 1966). And in certain
amphibians, development is known to involve the creation of inheritable,
irreversible nuclear (or chromosomal) changes within somatic tissue (see
Fischberg and Blackler, 1961), these changes possibly being deletions.
During lymphocyte differentiation in mammals, there is a regulation of
genomic rearrangement events in those cells (Alt et al., 1986). It is
well known that very high frequency, genomic changes involving somatic
hypermutation/intra-chromosomal recombination in developmental,
immunological tissues (B lymphocytes) occur as a controlled, adaptive
response to internal environmental stresses, such as bacteria and
viruses or other foreign antigens (Teng and Papavasilion, 2007; Ziqiano
et al., 2004; Mange and Mange, 1990). The developmental consequence is
diverse antibody production, which is adaptive.
In various plants, there are controlled changes in ploidy in different
cells during development (Bino et al, 1993; Galbrath et al., 1991). In
Nicotiana, controlled deletions of heterochromatin in somatic cells,
possibly involving intra-chromosomal recombination, occur frequently
during development, which results in color variegation of the flowers
(Burns and Gerstel, 1967). In maize, some features of development are
based on a transposition-insertion-deletion, controlling-element system,
with many variations of such (McClintock, 1951, 1965). Dr. McClintock
proposed that many other aspects of maize development could be so based,
as well. As in Aspergillus, such a system in maize derived from a
chromosomal or karyotypic reorganization Such a system in maize and its
variations are temperature and age sensitive.
These developmental systems have characteristics suggesting their
evolution from responsive, karyotypic-based mutators. It is likely that
other developmental systems having occurred through the evolution of
environmentally responsive, changing karyotypes and based on innerlly-controlled,
refined genomic changes, controlling genetic expression, will be
demonstrated. Such a system of refined, controlled genomic changes could
involve the excision of genetic regions, the transposition of such, and
their re-insertion into other sections of the genome. It is not
difficult to imagine the evolution of such a refined system from a
karyotypic-based mutator system, where in such a refined system, genetic
material is not lost in most cases, but excised, transposed, and
re-inserted, with developmental effects on higher levels of
organization. The earlier and interim stages of such an evolution may be
exemplified in many current organisms.
Hence, it is predicted that more and various karyotypic-based mutator-systems,
responsively generating or leading to frequent adaptive, inheritable
changes in differentiation and morphology within short periods, will be
detected in various organisms. As with the Aspergillus system, these
mutator-systems may form the basis for the future evolution of more
complex and refined developmental and growth pattern systems, leading to
more adaptive and, in many cases, productive organisms. This would
include cultivated and nurtured plants used in agriculture and
horticulture, but among the harmful, could include organisms that are
pathogenic to such plants, as well. There is the likelihood that the
environmentally responsive mutator systems in bacteria, Aspergillus and
maize are genetically related through evolution (Lieber, 1998).
This makes the
aforementioned prediction even more feasible. The developmental, Ac-Ds
controlling-element system in maize is very similar to the dual mutator
system in Aspergillus (Lieber, 1972,1976b). The adaptively responsive
phenomenon exhibited by Aspergillus (once classified as a lower plant)
strengthens the case for the widespread occurrence of various types of
adaptively responsive mutagenesis in various organisms. This gives
greater feasibility to the conclusions stemming from those earlier
investigations of adaptively responsive mutagenesis. The developmental,
adaptive system in Aspergillus makes the following situation even more feasible. Namely,
environmentally responsive, inheritable mutator systems of various
types, especially those with developmental features, have played a
significant role in a responsively accelerated, adaptive, developmental
evolution. This would pertain especially to the evolution of animals and plants, including the progenitors
of cultivated crops and of pathogenic organisms.
Predicted Responsive Mutator System
In fact, what appears to be a variation of such predicted situations, as
described above, was recently described in April, 2014. When a soil
fungus pathogenic to rice was subject in one experiment to increasing
copper concentrations, which increases are normally toxic to the fungus,
and to temperature shocks in other experiments, significant genomic
rearrangements occurred in response to both types of stresses via the
agency of transposition elements or TEs (Chadha and Sharma, 2014.) With
increasing concentrations of copper in the culture medium, the fungal
colonies became resistant, and were able to grow, which was correlated
with increased or frequent genomic change through the insertion of
certain TEs. Moreover, increased copper resistance was associated with
frequent color changes of the colonies from grey to white, the changes
appearing as white sectors in photographs, and also judging from the
photographs, morphological changes were also generated. As noted by the
authors, colonies adapted to the highest copper concentration exhibited
dense aerial hyphae. Those colonies were completely white. In earlier
investigations by these authors, temperature shocks or stresses affected
fungal growth and resulted in morphological transitions such as pigment
changes and the production of aerial hyphae (Personal Communication.)
These responsive, frequent genomic changes to stress appeared to have
occurred over a short period, as implied by the data. Under field
conditions, where there are high concentrations of copper in the soil in
which the fungus resides, and the soil is very warm due to a tropical
environment, this fungus exhibits a high degree of genetic diversity or
genetic rearrangements, "suggesting [according to the authors] that high
copper content of soil and temperature stress are among the important
environmental factors responsible for the high genetic diversity of the
pathogen under field conditions." The further implication is that such
adaptive, genetic diversity was responsively induced via TEs over a
short period.
They state: "Whereas, extensive research over the last several decades
has elucidated numerous molecular responses to stress, it is much less
known how these translate into organismal–level responses." They suggest
that environmentally responsive TEs reflect such a translation. Does the
color and morphological change of the colonies with regard to copper
concentration also reflect such a translation? Recall in this
connection, that a process involving transposition elements may also
have been involved in the adaptively responsive mutator situation in
Aspergillus nidulans, where frequent adaptive changes involving
color-pattern differentiation, growth and morphology were generated over
a short period. In support of such involvement of controlling elements,
transposition of genetic elements, thought to be tandem duplications,
from chromosome to chromosome in Aspergillus nidulans induced
morphological and pigment changes, as brown sector variants, within short periods (Azevedo and
Roper, 1970.) These transposing elements responsible for those
phenotypic changes in Aspergillus diploids had their source in a duplication derived from Dp I.
Whether or not such phenotypic changes, based on such small, mobile,
karyotypic segments, were adaptive was, however, not investigated.
Yet, studies by the author showed that
intermediate temperatures of 39.5 degrees C and 36 degrees C, as opposed to temperatures of
42 degrees C and 28 degrees C, could significantly
increase, within a nine-day period, the frequency of generation of this
genetically based phenotype associated with Dp I (Lieber, 1972.). Moreover, the generation of these brown
variants were also associated with Dp III. The generation of these were confined to 42
degrees C, suggesting their enhancement by this high temperature.
Relevantly, in Aspergillus diploids having a
partial chromosome III segment in trans in triplicate gave rise repeatedly to haploid
derivatives having mutations on chromosomes I and V (Lieber, 1972.) Perhaps, such
chromosomal triplications in trans controlled the induction of such mutations through the
insertion of transposition elements into those chromosomes. Perhaps, such elements
originated from the triplications themselves. Such configurations could also have played
some role in an adaptively responsive mutagenesis.
The adaptive processes as reflected by internally regulated, frequent
karyotypic change and environmentally responsive TEs may only be markers
or shadows of a deeper, more encompassing adaptive dynamic; the
elucidation of which may give better insight into the translation
mentioned above. With this in mind, the following questions arise: How
and why would the environmentally responsive and innerly-controlled
karyotypic changes, mediated by TEs, develop into adaptive phenotypes?
What are the underlying connections that translate environmental cues or
stresses into adaptive, organismal, developmental responses, from
phenome to genome and through genome to phenome? The authors of the 2014
publication regarding the pathogenic fungus do point out that the TEs
investigated do behave in different ways and are highly specific;
responding differently to different environmental clues or stresses.
Again, what is the basis of such specificity of action leading to a
correct phenotypic adaptation?
VI. Conclusion. Towards Strengthening the New Paradigm with
Constructive Results
More Examples of Environmentally
Responsive Mutator Systems and What Their Existence Indicates
Though it appears karyotypic-mutator systems, through their own
environmentally responsive, inner-controlled instability, could have
adaptively evolved into many current developmental systems based upon
inner-controlled genomic changes involving transposing genes, thereby
having increased through time the implicit selection and evolvability of such systems, it is
still not clear in many ways as to how specific adaptive changes on various levels could
have been mediated during that evolution. In this regard, could a type of dynamic,
epigenetic imprinting due to various stresses, via cytoplasmic states, cellular membranes, the cytoskeleton and
nuclear matrix, on chromosomal behavior and architecture, be involved in
such specifically responsive adaptations? And could such an imprinting
account for a likely accelerated evolution of pathogenic organisms and
higher plants, through an epigenetic imprinting process regulating and
determining lasting karyotypic mutator influences on the very
developmentally-involved epigenesis? Most relevantly, and predictable in
this regard, inheritable epigenetic modifications in plants occur due to
environmental stresses (Boyko et al., 2011). Such inheritable, adaptive
epigenetic modifications, which the authors refer to as epimutations,
are associated with an increased frequency of genomic rearrangements,
whose generation appears to be non-random. Moreover, "epigenetic transgenerational inheritance of
altered stress responses" in rats is described by D. Crews et al, 2012.
Such a further evolved, environmentally responsive process in plants and animals could be
considered as a transgenerational, environmentally responsive
developmental system, perhaps a variation of genetic assimilation. It
would be one manifesting and occurring through dynamic connections
across different levels. As far as elucidating the dynamic underlying
such specific connections and interconnected adaptations on various
levels of organization, including the environmentally responsive,
transgenerational epigenetic-karyotypic level, one must look for more
interconnected, holistic and imaginative explanations, based on new
assumptions. One such assumption or hypothesis could assert a nexus of external and
internal forces imprinting or driving
stable-specificity through instability within and between cellular epigenomes or architectures,
coordinately and globally
shaping such architectures, where a maximum of dynamic uniformity in
non-uniformity would prevail, achieving maximum stability and completion
through all architectures, and through their force connections to the external environment. (See, Lieber, 1996.)
Such completion could involve the
reduction or resolution of internal stresses, such as non-uniform tensile stresses within various regions and periods,
through the generation of new, internal force configurations guiding development. (See Elder, 1990 for a
relevant account of the proposed reduction of tensile stresses within singularities in
ontogeny through cell movements in morphogenesis.) In another account, the reduction of
non-uniform tensile stresses and pressures during frog development occurs through the
cell movements of morphogenesis. Such movements, guided by the non-uniform tensions and
pressures, ensue in the establishment of a equilibrium of forces in the regions of the
completed morphogenesis (Cherdantsev et al., 1994). Morphogenesis is guided by non-uniform
stresses and resolves them. These explanations, pertaining to dynamic completion, could and should be
tested by experiment in order to gain a more complete, empirically-based
picture and so enable scientists to arrive at a heuristic, universal
principle in biology.
In his 2011 publication,
and in related articles, the geneticist, James Shapiro, speaks of "natural genetic
engineering systems" in which highly controlled or regulated genomic
rearrangements on different scales occur in bacteria, fungi, plants,
insects, and mammals, especially in controlled and creative response to
various types of stresses. As he illustrates, in the past, these
non-randomly generated rearrangements in response to environmental
conditions could have been transmitted through subsequent generations, thus defining
and enhancing
evolution, especially enhancing the creative capacity for organisms to
have
evolved adaptively in response to environmental stresses. The Aspergillus dual mutator system, through its
responsive developmental features, would be a prime example of a natural
genomic engineering system. In referring to the dual mutator system in Aspergillus, Dr.
Shapiro stated in a personal communication: "I completely agree with you about the
environmental responsiveness of genome operators."
Dr. Shapiro demonstrates,
importantly, that in various organisms
under stress the engineering of genomic change has, in many cases,
repeatedly involved the specific, regulated patterns of transposon/retotransposon
excisions and insertions into critical genomic regions, modifying
genomic/chromosomal organization, at times involving chromosomal rearrangements
at higher scales and genomic amplifications,
and, in so doing, regulating genetic expression through different
organizational levels. as well as determining genomic imprinting. He describes how this could be controlled
or directed epigenetically at the cellular level utilizing inclusively
various molecular, non-linear signaling networks. If I understand him correctly, such
inner-directed epigenetic processes, responsive creatively to environmental stresses by
incorporating them, ensue in
inheritable, adaptive phenotypes in evolution.
However, as is the case
with regard to the relationship between karyotypic change and
morphological evolution, it is not clear
how these networks are arranged and function hierarchically in
organismic architecture through various levels of organismic
organization to generate a responsive differentiation and morphogenesis,
which is adaptive. Relatedly, it is also unclear how these ordered, molecular signaling
networks connect to
or involve the capacity to effect adaptive changes at the phenotypic level of organization. Nor does the heritability of
the capacity to effect such
responsive patterns of changed phenotypic characteristics appear to be addressed
clearly through the coordination of such non-linear networks.
Specifically, how do
such networks define and implicate developmental mutator- systems and
their phenotypes, which through their own controlled instability at
different levels, evolve into the effective developmental systems of
various organisms. Also, responsive transposons can induce inheritable
changes in morphogenesis in Drosophila, as pointed out by Dr.
Shapiro. Yet, how does the conception of molecular networks apply to
this type of situation. What is the hierarchal connection between such networks, their
environments, and
the evolving capability for the evolution of an adaptive, dynamic
geometry of morphogenesis. In effect, how do these networks determine
and define responsively the dynamic, capacity of organisms
to evolve adaptively in time through all geometrical levels.
A responsive transcalar epigenome, hierarchically and dynamically flexible involving
specific, structuring/shaping force-configurations as signals, must be involved in some
intricate and geometrically unifying way, through and accounting for all
levels of organization. These shaping force-configurations or force-fields of biological
geometry or manifolds, possibly driving towards dynamic stability and reduced stress through all levels
of the organism in its connection to its environment, would be mediated and enabled
epigenetically, perhaps at times, more karyotypically than
epigenetically. Though with the exception of three publications (P. Lieber,
1969, M. Lieber, 1996, and M. Lieber, 2006), a unifying principle to explain the why and
how of this appears to be lacking in current, even holistic, biological
thought and one that may be demonstrated in
future research. It appears Professor Shapiro sees this in some way, as
he writes, "At present, our understanding of basic principles governing
this overall control architecture is severely limited, and it certainly
deserves to be a prime subject of 21st Century research." (Shapiro,
2011).
Knowing such a principle or principles may enable scientists to counter or reverse the
generation and evolution of pathogenic organisms and promote the
evolution of pathogenic resistance in crops, as well. Be this as it may,
and pointing to aspects of such a principle, environmentally responsive
and innerly-controlled, adaptively changing karyotypic-mutator systems,
involving transposons, could have provided the inner dynamic and
capacity for various, enhanced macro- and micro-evolutions of various
organisms and their developmental processes over relatively short
periods. Using tissue culture methods, the creation and application of
such mutator systems in an epigenetic context, involving transmitted
energies and stresses, may even become a significant parameter in a
near-future evolution, through genetic engineering, of more productive
and age-resistant plant-cultivars with altered, adaptive developmental
and growth pattern systems. These would be developmental changes and
features analogous to those generated by the mutator-system in
Aspergillus.
Evolution as a Responive Stabilzation
Process to Stress Through Environmentally Responsive Mutators
Operating on Different Levels of Genomic Organization while Influencing
Phenotypic Development
The Aspergillus-mutator-system is an early and significant
example (effectively in 1972) of an internally regulated hypermutator-system
in a multicellular organism enabling, quick adaptive responsiveness, on
various levels of organization, to new environmentally-induced
conditions in the organism, and thereby innerly and developmentally
evolutionary. The Aspegillus-mutator-system can certainly be seen as
being within an epigenetic system guiding, and being cyclically
influenced by, inner mutator processes, and one most likely prone to
inheritable imprinting.
This would be a type of mutator-based, multilevel epigenetic system
probably forming the evolved basis for many, present day developmental
and growth-pattern systems, at least significant features of such, where
controlled genomic change through responsively regulated genetic
deletion, transposition and re-insertion could be involved in many
situations. Of course in many cases, regulated gene activation and
suppression occur as features of development. Yet, such genetic behavior
is dependent on chromosomal configurations or states, such as
heterochromatin and methylation. And, predictably, these could very well
be epigenetically controlled, and controlling, through the
environmentally-influenced deletion, re-insertion and expression of
genetic factors, such as transposons, a process representing a type of
position effect variegation through regulated intra-chromosomal
behavior. Modern genetic research has provided supportive evidence of
this (Ito et al. 2016), giving further support to the predictions
presented in this article.
As shown by Ito et al., an epigenetic system in a higher plant can
induce enhanced, inheritable, and adaptive mutation, through transposon
insertion, enabling seed germination in response to a chemical stress in
the culture medium that inhibits such germination in culture. This is an
evolved, mutator-based system controlling development across
generations, in which, transposon activity in progeny must also be
induced or enabled by heat treatment of the parental generation: Such
prior heat treatment of the parent plant, and ensuing transposon
activity within the parent, also enables responsive transposon activity
to a chemical stress in seed progeny, promoting their germination.
Namely, the chemical-stress induction of beneficial mutations enabling
seed germination, through the chemical-stress-responsive insertions of
transposons into specific genes within the seed-progeny, requires prior
heat treatment of the parental generation.
Thus, heat stress itself would seemingly be acting or being utilized in
a potentating-mutagenic, epigenetically adaptive fashion across
generations, necessary for transposon-induced germination of seeds.
However, an implicated, controlling methylation of the inserted
transposons---where methylation is under the regulation of another
genetic region within the system---can inhibit the expression of the
adaptive mutations, ensuing in re-sensitivity to the chemical stress,
whereby germination again becomes inhibited. Subsequent heat treatment
of the seeds reactivates the expression of the beneficial mutations,
controlling germination, ensuing in the re-activation of germination, as
well as the expression of genes.adjacent to the beneficial ones. This
occurs through heat-induced demethylation of the inserted transposons
that created the beneficial mutations and heat-induced demethylation of
adjacent regions.
The regulated methylation could mask the effect of such mutant genes in
vivo when conditions would require plant dormancy. Under such cold
conditions, as their research implies, the effect of the mutant genes
would be non-adaptive but adaptive under warm conditions or heat. The
chemical stress is in fact a plant hormone that induces dormancy under
cold conditions. In view of this, the evolved epigenetic control of
mutant induction and expression would quickly be able to accommodate
plants to changing environmental conditions, allowing for and inhibiting
development when respectively necessary, and in a heritable fashion. And
as noted, induced karyotypic change can cause genetic deletions and gene
silencing in plants (Pikaand, 2001), which could be adaptive. Even
though all the adaptive dynamics across different levels of organization
have not been clarified in various studies, the predicted systems or
processes such as these can nevertheless be seen as also contributing to
the beginning stages of a new paradigm for mutation and evolution.
A New Paradigm for Biology?
A new paradigm encompassing rapid, non-random mutation and evolution not only becomes
creditable but very feasible. As viewed through this paradigm change,
environmentally responsive, enhanced genetic mutation on various genomic
levels of architecture can occur while defining or structuring levels of
biological evolution so guided responsively via epigenesis by that
mutation. This would be, through mutator-processes, an inner-regulated,
responsively enhanced mutation to stresses. Thereby, this would have
been a mutator-defined mutation enabling and controlling the rapid and responsively
accelerated evolution of organismal, developmental capabilities and
their expression. As the studies of the Aspergillus hypermutator-system
indicate, these environmentally responsive, regulatory mutator systems
could have themselves evolved in response to stress to become even more
effective, responsive sources of beneficial mutations, underlying the
increasing capacity for increasingly adaptive
developmental evolution. Through such inner-operating mutator systems
with developmental, responsive features, the evolvability of evolution
would have become greatly enhanced through time, and this will probably
continue into the future.
In an investigation of bacterial evolution, hypermutators were found to
generate, through many bacterial generations, increasing frequencies of
adaptively beneficial mutations in response to increasing levels of
alcohol stress. Some were far more effective and faster in doing so than
others. When the stress subsided for the bacteria, that is when the
bacteria became adapted, the hypermutators ceased to generate the
mutations (Swings et al., 2017). As the data suggests, such mutators
could have themselves evolved in response to stress so as to become more
effective and quick generators of beneficial mutations, enabling
adaptation to severe stress. Even in a lower organism, this shows types
of developmental systems, controlling mutation, quickly responsive or
"adaptively tuned", as the authors would put it, to changing
environmental stresses, some severe. This very capability, to regulate
or promote adaptively responsive mutation to stress, itself responsively
and adaptively evolves, as could have karyotype-based mutator systems. In their studies, this evolvability of
controlled mutation was also reflected on the molecular level. On this
level, these regulated mutations occurred through mismatch repair or
misrepair of DNA sequences. In 1989, it was proposed that misrepair of
DNA sequences due to transposon insertion into the bacterial chromosome was
involved in a global, inner-controlled hypermutation in bacteria, also
argued to be environmentally responsive (Lieber, 1989). Responsive mutators, with
developmental features, would appear to have been operating at all genomic levels in all
types of organisms. This would have a significant bearing on evolution.
Environmentally responsive mutators, in
various organisms, operating on different hereditary levels, from the molecular-genetic to the genomic/karyotypic,
or even trans-genomic or epigenomic, could have enabled a hierarchy of evolution. This could have allowed
for the rapid and simultaneous creation of new organisms on various taxonomic levels.
Goldschmidt in 1940 did argue for a hierarchy of evolution based on changing karyotypic structures or
chromosomal patterns that modified development. This view would appear to suggest that such a hierarchical,
multi-dimensional evolution
could have had an inner parameter, which might be construed as having developmental
features. Such would also have had bearing on the evolution of behavior and the capacity for
abstract symbolization in humans. As Jablonka and Lamb illustrate (2014), evolution has had
four dimensions, namely the genetic, epigenetic, behavioral and that of symbolization. Such
dimensions are illustrated as being environmentally responsive and interactive with one
another, generating adaptive
variation along their respective, mutually influencing avenues. All
of these mutually contigent avenues would themselves have had environmentally responsive, developmental features through space-time.
From what we have seen, on a deeper, more inclusive level, the evolution of developmental and growth pattern
systems would appear, in fact, to have an inner, ordering, stabilizing dynamic or
component capable of quickly accommodating adaptively to environmental
and internally-related epigenetic stresses, which tend to destabilize,
and which in this context are mutagenic. Such accommodation, however, would involve the
stable assimilation and reduction of those very stresses into the dynamic configurations and architectures
of all organisms, and thereby the development of adaptive phenotypes across many
generations.
Evolving organisms are
adaptively tuned to stresses through inner-regulated, environmentally
responsive mutator-systems, enabling the organisms' adaptive
stabilization though space-time and across many generations. Thus, evolution itself, on
different levels, would appear to be a stabilizing,
trans-generational, evolving developmental process, enhancing the very
effective capacity of such a process to evolve, countering
destabilization via multilevel, mutator-controlled, environmentally
responsive mutation, through space-time. Such a developing, inner drive to evolving
stabilization or dynamic completion could also be construed as an
implicit, inner-driven, evolving selection process.
This would be a selection
having a deeper, subtler, and more encompassing meaning than the one used
traditionally in connection to discussions about evolution. It
would be a selection manifesting an increasing, inner capacity, enabled
by an evolving environmentally responsive, inner directed mutator
architecture, for adaptive evolution. This and the perspective
presented in this article would not only
have significant implications for agricultural research, such as crop
improvement, but could guide medical research, as well. Furthermore, it
would give deep insight as to what it means to be human and to what our
biology and minds mean for our own future evolution. Do we evolve so as
to overcome our own limiting, destabilizing and destructive constraints?
What future realities does our greatly enhanced, mutator-based evolvability foresee for
us?
Michael M. Lieber, August, 2014, December, 2015. and July, 2017
Photographs of Aspergillus Colonies with Dual Mutator
Colonies of Aspergillus nidulans from a large group of colonies each
having produced through a karyotypic, dual mutator system many mutant yellow
sectors in response to a temperature stress. The improved morphology,
growth-rate, and conidial production of such sectors would indicate an
adaptively responsive, inner-directed mutagenesis to temperature stress.
This would be an environmentally responsive hypermutation expressed
phenotypically as a new pattern of differentiation encompassing
morphological change within sectors. Also, note in the bottom photograph
the two white sectors of normal morphology and improved, linear growth rate.
These arise due to mutations within a gene epistatically controlling the
production of colored conidia. Such sectors were only generated, though
infrequently, in the strain with the two partial duplications in the
genome. Their generation in this situation might have been due to the
insertion of a small genetic element deleted from the reduced Dp III into (or very near to)
the epistatic gene on chromosome II, resulting in the suppression of
pigment production. Such insertion would have been in concurrence with
deletions that would have otherwise produced yellow sectors.






Home
References
Alt, F. W. et al. (1986). Regulation of genomic rearrangement
events during lymphocyte differentiation. Immunol. 89: 5.
Azevedo, J. L. and J. A. Roper. (1970). Mitotic non-conformity in
Aspergillus: successive and transposable genetic changes. Genet. Res.
16: 79-93.
Beerman, S. (1966). A quantitative study of chromatin diminution in
embryonic mitoses of Cyclops fureifer. Genetics 54: 567-576.
Bino, R.J. et al. (1993). Flow cytometric detection of nuclear
replication stages in seed tissue. Annals of Botany 72: 181-187.
Boyko, A. and Kovalchuk, I. (2011). Genome instability and epigenetic
modification - heritable response to environmental stress. Current
Opinion in Plant Biology 14 : 260-266.
Chadha, S. and M. Sharma. (2014). Transposable elements as stress
adaptive capacitors induce genomic instability in fungal pathogen
Magnaporthe oryzae. PLOS One 9, No. 4: 1-14.
Cherdantsev, V.G. and Scobeyeva, V.A. (1994).
The morphological basis of self-organization. Development and evolutionary aspects. Rivista
di Biologia/Biology Forum 87 (1): 57-85.
Cherry, L., M. Lieber, and A. Wilson. (1978). Phylogenetic analysis of chromosomal evolution
in vertebrates. A Report submitted to the Proceedings of National Academy of Sciences USA.
Crews, D. et al. (2012). Epigenetic
transgenerational inheritance of altered stress responses. PNAS 109 (23): 9143-9148
Elder, D. (1990). Polarity, singularities and
morphogenesis. Rivista di Biology/Biology Forum 83 (2-3): 397-403.
Feldman, M. and Levy, A. (2009).
Instantaneous genetic and epigenetic changes in wheat genome caused by allopolyploidization.
In Transformation of Lamarckism: From Subtle Fluids to Molecular Biology, Chapter 25.
Edited by S. Gissi and E. Jablonka. . Vienna
Series in Theoretical Biology.
Fischberg, M. and Blackler, A.W. (1961). How cells specialize.
Scientific American 205 (3): 124-132.
Galbraith, D. W. et al. (1991). System endopolyploidy in Arabidopsis
thaliana. Plant Physiology 96: 985-989.
Goday, C. and Estaban, M.R. (2001) Chromosome elimination in sciarid
flies. Bio Essays 23 (3): 242-250
Goldschmidt, R. (1940). The Material Basis of Evolution, Yale University
Press.
Ito, H. et al. (2016). A stress-activated transposon in Arabidopsis
induces transgenerational abscisic acid insensitivity. Published online
in Scientific Reports 6. Article number 23181.
Jablonka, E. and Lamb, M. (2014) Evolution
in Four Dimensions: Genetic, Epigenetic, Behavioral, and Symbol Variation in the History of
Life. Revised edition, MIT Press.
Lieber, M. (1967). Mutation, Development and Evolution. Thesis.
Institute of Animal Genetics, University of Edinburgh.
Lieber, M. (1972). Environmental and genetic factors affecting
instability at mitosis in Aspergillus nidulans. Ph.D. Thesis, University
of Sheffield.
Lieber, M. (1975). Environmental and genetic factors affecting
chromosomal instability at mitosis and the importance of chromosomal
instability in the evolution of developmental systems. Evolution Theory
1: 97-104.
Lieber, M. (1976a). The effects of temperature on genetic instability in
Aspergillus nidulans. Mutation Res. 34: 94-122.
Lieber, M. (1976b). The genetic instability and mutagenic interaction of
chromosomal duplications present together in haploid strains of
Aspergillus nidulans. Mutation Res. 37: 33-66.
Lieber, M. (1989). New developments on the generation of mutations in
Escherichia coli lysogens. Acta Microbiologica Hungarica 36(4): 377-413.
Lieber, M. (1990). Mutagenesis as viewed from another perspective, Riv.
Bio./B. Forum 83 (4): 513-522.
Lieber, M. (1996).
Force, development, and neoplasia: Development from another perspective
as illustrated through a study of in vitro plant development from
neoplasm. Riv. Biol./B. Forum 89: 245-274.
Lieber, M. (1998). Environmentally responsive mutator systems: toward a
unifying perspective. Riv. Biol./B. Forum 91: 425-458. (View
PDF of Article.)
Lieber, M. (2006).
Towards an understanding of the role of forces in carcinogenesis: A
perspective with therapeutic implications. Riv. Biol./B. Forum 99:
131-160.
Lieber, M. (2011. The problem of antibiotic resistant bacteria. The
important role of environmentally responsive mutagenesis, its relevance
to a new paradigm that may allow a solution. Theoretical Biology Forum.
104, No. 1: 91-102.
Lieber, P. (1969).
Aspects of evolution and a principle of maximum uniformity. In C.H.
Waddington (ed.) Towards a Theoretical Biology II, Aldine
Publishing Company, Chicago.
Lindegren, C. (1966). The Cold War in Biology, Planarian Press.
Mange, A. and Mange, E. (1990). Genetics: Human Aspects, Sinauer Assocs.
Sunderland, Mass.
McClintock, B. (1951). Chromosome organization and genic expression.
Cold Spring Harbor Symp. Quant.Biol. 16: 13-47.
McClintock, B. (1965). The control of gene action in maize. Brookhaven
Symp. Biol. 18: 162-203.
Nair, A. and Deardon, P. (2016). Waddington's
assimilation, a fact or mere philosophy shaped in the Lamarckian mold: A genomic inquiry.
Eliven: Bioinformatics 3(1): 001.
Piaget, J. (1974). Biology and Knowledge, University of Chicago Press.
Pikand, C.S. (2001). Genomic change and gene silencing in polyploids.
Trends in Genetics. !7, No. 12: 675-677.
Prud'homme, B. et al. (2007). Emerging principles of regulatory
evolution. Proceed. Nat. Acad. Sci. USA. 104, supp 1:8605-8612.
Shapiro, J. A. (2011).
Evolution: A View from the 21st Century. FT Press Science, Upper
Saddle River, New Jersey. Personal communication via e-mail of his short
article: "Diverse ecological impacts on natural genetic engineering."
Suzuki, Y. and Nijhout, H.F. (2006). Evolution of a polyphenism by
genetic accommodation. Science 311: 650-652.
Swings, T. et al., 2017. Adaptive tuning of mutation rates allows fast
response to lethal stress in Escherichia coli. eLife 2017;6:e22939. DOI:
10.7554/eLife.22939
Teng, G. and Papavasilion, N. (2007). Immunoglobin somatic hypermutation.
Annual Review of Genetics 41: 107-120.
Vanneste, k., S. Maere, and Y. Van de Peer. (2014). Tangled up in two: a
burst of genome duplications at the end of the Cretaceous and the
consequences for plant evolution. Phil. Trans. R. Soc. B. 369, No. 1648
20130353.
Waddington, C. H. (1953). Genetic assimilation of an acquired character.
Evolution 7: 118-126.
Waddington, C. H. (1956a). Genetic assimilation of the bithorax
phenotype. Evolution 10: 1-13.
Waddington, C. H. (1956b). Principles of Embryology, p. 352. G. Allen
and Unwin Ltd, London
Waddington, C. H. (1959). Canalization of development and genetic
assimilation of acquired characters. Nature 183: 1654-1655.
Wilson, A.C. et al. (1977). Biochemical evolution. Annual Review of
Biochemistry 46: 573-639.
Yadav, V. et al. (2019). Cellular dynamics
and genome identity of centromeres in ceral blast fungi. ASM Journals/m bio/Vol. 4. DOI,
https: //doc.org/10.1128/mBio.01581-19
Ziqiano, L. et al. (2004). The generation of antibody diversity through
somatic hypermutation and class switch recombination. Genes and
Development. 18: 1-11
Biography
Addendum I
Though technically considered single-cellular organisms, bacteria and
yeast grow into colonies of many cells. Shapiro (1988) argues that
bacteria should be considered as multicellular organisms. Nevertheless,
compared to Aspergillus nidulans, they would still be very simple
multicellular, undifferentiated organisms. As noted, non-growing
colonies of bacteria subject to a particular, nutritional stress
produced mutations in single cells that gave rise to protruding, growing
sectors of cell clones adapted to the nutritional stress. These sectors
stain red while non-growing colonies from which they emerge are white.
The production of such adaptive sectors under stress is very analogous,
if not related, to the production of the mutant, adaptive yellow sectors
in the colonies of the Aspergillus-mutator strain. This is especially so
as the production of such adaptive sectors by the non-growing, stressed
bacterial colonies was under internal, genetic control involving the
excision of insertion elements from a regulatory gene (Hall, 1988).
This internal, genetic control responsive to environmental stress might
reflect a very early form of developmental system displayed by the
bacterial colonies. It would be a basic system producing adaptive
sector-variegation or differentiation throughout the colonies by means
of responsive, controlled genetic change. Each such colony with
genetic-based, responsive, adaptive variegation might be considered as
an adaptive, developmental whole or unit. This very early developmental
system in bacteria might very well have evolved into developmental,
karyotypic mutator-systems such as exhibited by the Aspergillus system
and possibly in other, higher organisms, such as maize. In this regard,
suggesting a developmental process, a two-part mutator system in
bacteria, adaptively responsive to environmental, nutritional stress
exhibited temporal control of the occurrence of adaptive mutations (Lieber,
1989, 2001).
This temporal process involved transposons and recombination based on a
mutant gene. In related studies with bacterial strains having a two-part
mutator system involving transposons and recombination based on a mutant
gene, directed, programmed mutagenesis in eight different bacterial
strains enabled the same high frequency of growing colonies (within a
short period) of each strain on respective media lacking the same group
of amino acids for which the respective strains were genetically
auxotrophic. This was in contrast to the response of auxotrophic, non-mutator
strains. In effect (and implicitly), this represented adaptively
responsive, directed mutation uniformly connected to overcoming the same
multiple nutritional stresses within a short period, where transposition
and recombination were involved (Lieber, 1989, e.g., pages 399, 391 and
385; Lieber.1998). Compared to the frequency of spontaneous mutations
that would enable growth to the same group of amino acids under
non-selective, non stressful conditions, the frequency of mutations,
involving transposons, conferring adaptation under the nutritional
stresses, would be exceedingly high.
Regarding transposon control, it was proposed in 1989 that this type of
adaptively responsive mutagenesis occurred through misrepair of DNA due
to the physical distortions of the bacterial DNA chromosome arising from
the insertion of transposons into the chromosome (Lieber, 1989). Recent
research has shown that adaptively responsive, increasing hypermutation,
over many generations, enables many bacteria exposed to increasing
alcohol stress, over those generations, to survive. Such beneficial
mutations, promoted by the mutators, have occurred quickly in great
frequency through the regulatory mutators promoting mismatch repair (or
misrepair) of DNA sequences within the bacterial chromosome. (Swings et
al., 2017). As the authors also point out, when the bacteria become
adapted to the severe alcohol stress, thereby being no longer under
stress, the hypermutation ceases. In view of these different
investigations, responsive, developmental features were clearly
indicated within varying levels of adaptively responsive mutagenesis
tuned or connected to various degrees of environmental stresses.
With regard to the earlier research on hypermutagenic colonies, each
growing colony would represent an outcome of a subpopulation of stressed
cells within a manifold of non-growing cells on the culture medium,
which, through hypermutability of their genomes linked to the
nutritional stresses, became adaptive to the stresses. These growing
colonies would represent variegation within a sea or manifold of
stressed, non-growing cells. This manifold with adaptive, growing
variegations might be likened to a macro-colony undergoing
inner-controlled, adaptive variegation or differentiation. This would
make such a macro- colony a developmentally responsive entity, in many
ways related to the adaptively responsive Aspergillus colonies through
their environmentally responsive variegation/differentiation. This might
suggest deep evolutionary, regulatory connections between bacteria and
the fungi.
Very simple colonial organisms have, it would appear, inner mutator-systems
capable of evolving into complex, environmentally responsive mutator-systems
in relatively higher organisms, such as in Aspergillus and maize (See
Lieber, 1998). Environmentally responsive mutator-systems with
developmental features of various complexities appear to have been
pervasive throughout the evolution of life through their own evolution.
The evolution of such developmental mutator-systems from earlier,
simpler ones to more complex ones would have given a further inner,
evolving evolvability to evolution.
References
Hall, B. (1988). Adaptive evolution that requires multiple spontaneous
mutations. I. Mutations involving an insertion sequence. Genetics 126:
5-16.
Lieber, M. (1989). New developments on the generation of mutations in
Escherichia coli lysogens. Acta Microbiologica Hungarica 36(4): 377-413.
Lieber, M. (1998). Environmentally responsive mutator systems: toward a
unifying perspective, Riv.Biol./B. Forum 91: 425-458.
Lieber, M. (2001). Temporal control of environmentally responsive
hypermutation involving cryptic genes. Mutation Research 473: 255-257.
Shapiro, J. (1988). Bacteria as multicellular organisms. Scientific
America. June: 82-89
.
Swings, T. et al., 2017. Adaptive tuning of mutation rates allows fast
response to lethal stress in Escherichia coli. eLife 2017;6:e22939. DOI:
10.7554/eLife.22939
Addendum II
Originally the karyotypic, dual mutator system in
many green colonies of Aspegullus nidulans, having the reduced Dp
III along with Dp I in its genome and designated as strain h,
produced a very high frequency of programmed mutations at 36 degrees C
involving the gene for green color on Dp I, as exhibited or manifested by the
production, at the same time, of many mutant yellow sectors per colony (Lieber,
1976b, 1972). (Controls at this temperature having only Dp I produced a
mean of one yellow sector per colony.) Retrospectively considered, this lower temperature could
also have been stressful to Aspergillus strain/cultures having the dual
mutator system, ensuing in the production of a very high frequency of
mutant yellow sectors by the green colonies. The yellow mutant sectors
were of increased linear growth rate relative to the green colonies.
(See Figure 7.)
Also, see Figure 81
as well as Figure 88,
and Figure 78.
(These photos show four colonies from a large group of colonies having produced
a high mean number of yellow sectors. Such colonies were termed h
colonies or the h strain.). In view of this, an increasingly stressful
range of temperatures from 36 degrees C to 39.5 degrees C, enabling
adaptive mutation on the karyotypic level, is indicated.
Conidia, which gave rise
a-sexually to new colonies, obtained from the above cultures after their
storage at very low temperature for four and one-half months, gave rise,
however, to green colonies having a very low
frequency of mutant yellow sectors per colony at 36 degrees C. This frequency of mutant sector production was the same as that produced
at 36 degrees C by colonies only having Dp I, the uni-mutator strain
designated as P. (See Figure 3.) This frequency was a mean of one mutant yellow
sector per colony.
The first green, dual mutator strain h
had originally been derived from the green improved sectors produced by
another, newly generated, dual mutator strain, designated as RP-81.
RP-81 non-aged, colonies were grown at 36 degrees C.
RP-81* has partial duplications of chromosomes I and III in a haploid
genome. These green sectors of greatly increased linear growth rate are
indicative of deletions having occurred from the partial III,
chromosomal duplication, reducing its size or content, being
referred to as the reduced Dp III or the changed III duplication. (This was confirmed through genetic analysis, Lieber,
1972,
1976b.)
From such newly
generated green sectors produced by colonies derived from an aged strain of RP-81** through deletions, newly produced
conidia were isolated and used to produce new, green colonies of strain h at 36
degrees C. (Strain h has a reduced III duplication, reduced Dp III, and the
partial chromosomal I duplication, Dp I). These new colonies produced on average 3.4 yellow
sectors per colony. This frequency was significantly higher at P < 0.
01 than the mean frequency of such produced by strain P, which was a
mean of 1.1 sectors per colony. Though significantly higher than the frequency of mutant yellow sectors produced
by the uni-mutator strain P, this frequency was nevertheless far lower than the frequency of
such, which the original, non-aged, h strain had produced four and
half months
earlier. Moreover, the mutant sectors produced by this dual mutator strain four and one-half months later had not emerged at the same time,
suggesting the loss of the program control of mutation that was
displayed by its progenitor.
One of these h colonies,
h123, had produced many yellow sectors. Conidia from such was used to to
create another group of h colonioes at 36 degrees C., the group
designated as h123 colonies. This group of h123 colonies produced a mean
of 5.3 yellow sectors per colony.
Figure 1 below shows one of those
colonies. This mean was significantly higher at P< 0.01 than the
mean mutant frequencies of one yellow sector per colony.
Furthermore, when
h colonial cultures from new a-sexual conidia, isolated from newly
generated green sectors of newly cultured RP-81, were grown at the higher temperature of 39.5 degrees C, the
frequency of mutant yellow sectors greatly increased or enhanced. This
was a mean of 13.7 yellow mutant sectors per green colony, significantly higher
at P < 0.01 compared to the mean frequency of mutant sectors produced by the same strain
at 36 degrees C (3.4 yellow sectors per colony), and significantly higher at P< 0.01 compared to the
frequency of yellow mutant sectors produced by the uni-mutator strain at
39.5 degrees C,
which was a mean frequency of 5 yellow mutant sectors per colony.
(See Figure 2 below.)
Also, at this higher temperature, all mutant sectors emerged at the same
time from the h colonies, indicating the re-emergence of the
responsive, temporal program guiding the degree of mutation (Lieber,
1972, 1976b). The vertices of the yellow sectors being equidistant from
colony centers indicated that such yellow mutant sectors emerged at the
same time or nearly so. (See
images.)
As described (Lieber,
1972), some of these h colonies
cultured at 39.5 degrees C had produced far more mutant sectors per colony
compared to the mean number per colony of the group. From one of such
colonies, h126, conidia were obtained and used to produce new h colonies
cultured again at 39.5 degrees C and at 36 degrees C. These were
referred to as h126 colonies. P colonies, having the karyotypic,
uni-mutator, Dp I, were
also grown at 39.5 degrees C and 36 degrees C. The P colony groups at 36
degrees C and 39.5 degrees C respectively produced a mean of 1.2 yellow
sectors per colony and a mean of 5.4 yellow sectors per colony,
indicating that the uni-muator is also responsive to high
temperature.
The group of h126 colonies cultured at 36 degrees C
produced a mean of 3.8 yellow sector per colony. Those yellow
sectors had not emerged at the same time. The group of h126 colonies cultured at 39.5 degrees
C had produced a mean number of 21 yellow mutant yellow sectors per
colony, which at P < 0.01 was significantly higher from the means 3.8
and 5.4. And these sectors emerged from each h126 colony at the same
time, again demonstrating the re-emergence of the temporal program
governing responsive mutagenesis. (See
images) As pointed out then by this author, these results clearly
indicated that the dual mutator system was highly responsive to the
increase in temperature by generating a high frequency of mutations in a
highly programmed manner.
My conclusion at the time,
however, was that, in the dual mutator system, the mutagenic effect of
the reduced III duplication on the y+ region of the I duplication was
not more effective at this higher temperature than at the lower
temperature. This conclusion was assessed later to be incorrect or
incomplete. Especially, as this conclusion was inconsistent with a
repeated experimental finding: This was the re-emergence
of the temporal control of all, enhanced mutations (in the
double-duplication mutator strain) due to growth at that higher temperature.
In view of this, it is indicated that growth at this higher temperature
influenced the type of mutagenic interaction occurring between the two duplications. The
colonies involved, obtained from the conidia of a source colony noted
above, designated h126, were respective groups grown at high and
lower temperatures. The group of these grown at a higher
temperature produced a very high frequency of mutations from the I
duplication in accord with a temporal program. All of such mutations
occurred at the same time. Mutations occurring at the lower temperature
were far less frequent and did not occur within a specific period. (See
above.)
It would appear that
growth at the higher temperature created a physiological state that
enabled the reduced III duplication to enhance mutations from I
duplication in accord with a temporal program. This physiological state,
due to increased temperature, influenced the type of interaction between
the two duplications. Other types of physiologic states may also
have affected the interaction. These would pertain to the age of the
conidia and the age of tissues of sectors from which the h126 colonies
were ultimately derived. In this regard, the source colony, h126,
was newly generated and produced newly generated conidia from which the
groups of h126 colonies were obtained.
This source colony at the
higher temperature had produced many mutant, yellow sectors at the same
time, as noted earlier. This colony was from a group
obtained from newly generated improved sectors from RP81. Again, these
tissue and conidial, physiologic states may have also contributed to a
temporally enhanced mutagenic interaction between the reduced III
duplication and the y+ region of the I duplication. It is
important to remind the reader that P colonies having only the I
duplication did give rise to an increase in yellow sectors when such
colonies were grown at the higher temperature. However, this frequency
was far lower than the frequency of yellow sectors arising from the
double-duplication, mutator strain cultured at that higher temperature.
It is possible that this growth at the higher temperature of the P
strain produced a physiological state that enabled the increased
frequency of mutant sectors due to deletions from the only
duplication present, the duplication.
It was such interactions that enabled the controlled, programmed
increase of mutations in the double-duplication mutator strain, which
led to frequent yellow sectors. In effect, the globality of
genotypic-environmental interaction was manifested. Such a global
interaction, arising through experimental conditions, enabled the observation of
a real programmed mutagenic process in an organism.
As the evidence
indicates here, the stress of high
temperature, to which cultures were exposed under experimental
conditions, enabled or stimulated the karyotypic, dual mutator system to promote in a programmed
or controlled manner a very high degree of mutations, which appeared to be beneficial under
those conditions. A stress on the karyotypic, dual mutator genome can also operate,
it would appear,
through a lower temperature when the physiological effects of age are
not operating, resulting also in an environmentally responsive,
controlled, enhanced mutation. The particular physiological state
occurring through age-affected cultures would appear to have suppressed
a programmed, mutagenic response to stress. As the observations
indicated, growth at the higher or stressful
temperature negated such suppression, enabling the re-establishment of
an effective, programmed, mutagenic interaction between the components
of the karyotypic, dual mutator system.
Investigations
described in Lieber, 1976a, also showed that a green, karyotypic-uni-mutator strain of
Aspegillus, carrying only Dp I, can also respond mutagenically
to a high temperature, by producing yellow sectors of improved, linear growth
rate and morphology within a
later, narrow culture period. (Means of approximately 5 yellow sectors
per colony were observed.) However, within this uni-mutator, Dp I
system, there was not clear evidence of the specific type of
programmed mutagenesis that was operating in the dual mutator system. As
indicated in Lieber, 1972, 1976b and by the information presented
here, the reduced Dp III component of the dual
mutator system assumed the role of the regulator of the degree of
mutations involving the Dp I component, taking programmed control of the
Dp I uni-mutator when physiological/environmental conditions allowed or
induced. It is
theorized that outside of the laboratory, conditions in nature have
allowed and will allow such mutagenic processes to occur. It is thus
predicted that such mutagenic processes will continue to occur under
natural circumstances or conditions.
As demonstrated in Lieber,
1972 and 1976b, colony size or circumference is not a factor in
different mutation frequencies. As can be seen in the photos, only one
colony existed per culture plate. Equal numbers of colonies were used in
the respective experimental and control groups. The number of colonies
in each group was generally 40, though in one experiment 33 colonies
were studied in respective experimental and control groups. Colonies were cultured for 10-12 days.
In another addendum
to this article, the author intends to include written sections from
Lieber, 1972, which is the author's Ph.D. dissertation. This should
provide further support to the account and perspective presented in this
article.
*Groups of RP81 non-aged, colonies
cultured at 36 degrees C
produce mutant yellow sectors at respective means of about
three yellow
sectors per colony. The colonies were obtained from a newly isolated RP-81 strain. These yellow sectors generally emerge from the green
improved sectors produced by the RP81 colonies. In order for colonies,
which are derived from such sectors, to respectively produce very high
frequencies of yellow sectors, the colonies must arise or generate from
germinating conidia in the centers of the culture medium on Petri
dishes. This is described fully, with implications, in Lieber, 1972,
1976b.
**These RP81 colonies had come from
aged conidia of a stored RP-81 colony.
Figure 1
A colony of the dual
mutator strain h123 from a group of h123 colonies cultured at 36 degrees C for 10 days.
Related h colonies of this strain at 39.5 degrees C are presented in the
first group of photographs in this article.

Figure 2
A colony of the
uni-mutator, strain P, from a group of colonies grown at 39.5 degrees C
for 10 days. The mutant yellow sectors are of increased, linear growth rate and
improved morphology. Most appear to have arisen about the same
time during the later culture period. This would suggest that the uni-mutator, Dp I, is also capable of responding to a temperature stress
at a certain time when in the P genome. However, while in the h
strain or genome, its response to such stress can be greatly controlled
or programmed by the reduced Dp III. The P colonies grown at this elevated
temperature were also used as controls for the h colonies grown under
temperature stress.

Figure 3
A colony of the
uni-mutator, strain P, from groups of colonies grown at 36 degrees C for
10 days.

Figure 78
Cultured at 36 degrees C,
a colony of strain 78 (another colony from a group of h colonies), with
the dual mutator system in its genome. This lower temperature could
also have been stressful. More specifically, the dual mutator system is
likely responding in a controlled, mutagenic manner to a epigenetic
stress mediated by temperature and the related cytoplasmic/physiological
situation. This could be construed as being an internal stress connected
to genomic and environmental conditions. After 4.5 months, cultures
obtained from this colony (and others) via aged conidia, gave rise to
colonies at 36 degrees C in which the dual mutator effect has been lost
or suppressed, only to be re-activated in other h colonies through newly
regenerated conidia and a stressful, high temperature, creating a new
stressful epigenetic condition to which responsive, karyotypic mutator/phenotypic
adaptation occurs again.

Figure 81
Cultured at 36 degrees
C, a colony of strain h81(another colony from a group of h colonies),
with the dual mutator system in its genome. This lower temperature could
also have been stressful. More specifically, the dual mutator system is
likely responding in a controlled, mutagenic manner to a epigenetic
stress mediated by temperature and the related cytoplasmic/physiological
situation. This could be construed as being an internal stress connected
to genomic and environmental conditions. After 4.5 months, cultures
obtained from this colony (and others) via aged conidia, gave rise to
colonies at 36 degrees C in which the dual mutator effect has been lost
or suppressed, only to be re-activated in other h colonies through newly
regenerated conidia and a stressful, high temperature, creating a new
stressful epigenetic condition to which responsive, karyotypic mutator/phenotypic
adaptation occurs again.
Figure 88
Cultured at 36 degrees C,
a colony of strain h88 (another colony from a group of h colonies), with
the dual mutator system in its genome. This lower temperature could also
have been stressful. More specifically, the dual mutator system is
likely responding in a controlled, mutagenic manner to a epigenetic
stress mediated by temperature and the related cytoplasmic/physiological
situation. This could be construed as being an internal stress connected
to genomic and environmental conditions. After 4.5 months, cultures
obtained from this colony (and others) via aged conidia, gave rise to
colonies at 36 degrees C in which the dual mutator effect has been lost
or suppressed, only to be re-activated in other h colonies through newly
regenerated conidia and a stressful, high temperature, creating a new
stressful epigenetic condition to which responsive, karyotypic mutator/phenotypic
adaptation occurs again.

Figure 99
A second generation, dual-mutator strain
cultured at 39.5 degrees C. This colony is from a group of 40 colonies derived from one
colony obtained from the conidia of a h type sector, with a reduced III duplication and the
I duplication. The h type sector had been produced by a colony whose second generation genome is similar to that of
RP-81. These colonies, cultured for 12 days, produced a mean number of 15.1 mutant yellow
sectors per colony.

References
Lieber, M. (1972). Environmental and genetic factors affecting
instability at mitosis in Aspergillus nidulans. Ph.D. Thesis, University
of Sheffield.
Lieber M. (1976a). The effects of temperature on genetic instability in Aspergillus nidulans, Mutation Res. 34: 94-122.
Lieber, M. (1976b). The genetic instability and mutagenic interaction of
chromosomal duplications present together in haploid strains of
Aspergillus nidulans, Mutation Res. 37: 33-66.
Addendum III
As indicated previously,
there are many possible mechanisms or avenues whereby the dual mutator system in
Aspergillus operates in response to stress. With regard to the single mutator system in
Aspergillus, Dp I, the author proposed in 1968 that the insertion of a gene, uvs,
which is deficient in the repair of damaged DNA due to UV exposure into a Dp I genome, could enhance,
through its presence, the deletional instability of that
duplication strain, as marked by a significant increase in the frequency of
yellow sectors produced by green Dp I colonies. This hypothesis was to be tested as part of the author's proposed
graduate research at the Department of Genetics, University of Sheffield, England. However,
the author did not pursue this research, concentrating instead on investigations pertaining
to the dual mutator strain of Aspergillus. Others in that department did eventually pursue
that area of research, leading to its publication by Burr et al. in 1971 and 1982. As their
research showed, the addition of a given uvs gene, uvsB,
deficient in the function of gene repair, into the genome of the Dp I strain of Aspergillus, ensued,
through that gene's presence, in a
significant increase in the deletion of the genetic region containing the green pigment
gene, y+. This was reflected by a significant increase in the frequency of yellow sectors produced
by green colonies. Approximate means of 5 yellow sectors (of improved,
linear growth rates) per green colony were noted in experimental groups as
compared to approximate means of 1 yellow sector (of improved
linear growth rate) per green colony in the control groups,
which had the gene for DNA repair, uvs+. Through an additional experiment, the
role of the duplication in the stability was also indicated. In view of the mutagenic effect
of the uvsB gene, it is seen that this role can be influenced or modified by other
genetic factors in the genome, such as genetic repair systems. Culture temperature was 37 degrees C.
In the author's study of the effects of
culturing at high temperature, 39.5 degrees C, on deletional instability of the Dp I
strain with a normal repair system, approximate means of 5 yellow sectors (of improved,
linear
growth rates) per green colony were
observed in experimental groups as opposed to approximate means of 1 yellow sector (of
improved growth rate) per green
colony in control groups, the latter being cultured at 36 degrees C. It was concluded that
culturing at a increased temperature enhanced deletional instability, namely, an increase in
the frequency of deletions including y+ (Lieber, 1976a). The identity between the degree in
increased instability due to deficient DNA repair in a Dp I strain because of the presence
of a repair-deficient gene, uvsB, in the Dp I genome, with the degree of increased
instability of a non-uvs, Dp I-strain, due to an increased temperature, now suggests
that culturing at an increased temperature also impaired DNA repair, leading to increased
instability. As the increase in yellow sector frequency at 39.5 degrees C occurred within a
narrow period
during late growth of the green colonies, it is suggested that the impaired genetic repair process
was subsumed or coordinated under some type temporal program.
At the time, in 1976, one conjectured that
increased temperature increased heterochromatization during a specific or narrow period, and that increased deletion occurred
through such. Now, perhaps, one can also conjecture that increased heterochromatization
within the genome inactivated genes (uvs+) responsible for genetic repair, leading to
increased deletion at the higher temperature. Also, distortion of cytoplasmic membrane
structures due to increased temperature, where mRNA translation is anchored, might have also
inhibited the production of repair enzymes through a destabilizing of the anchoring.
All of this would be worthy of further
investigation, especially a study of the effects of uv-deficient, repair genes on the dual
mutator system at various temperatures. It is likely that genetic repair systems underlie,
while being subsumed by, in
some manner the controlled, adaptively responsive mutagenic behavior of the dual mutator
system in Aspergillus, especially with regard to stress. However, it is presently unknown
how and why this is the situation. The existence of such repair systems do not explain the
programmed, mutagenic behavior of the dual mutator strain in response to temperature
stress. Though, it appears that the existence of such genetic repair systems, at some basic
molecular level, nevertheless, must enable such responsive, programmed mutator processes to
occur at higher levels of organization, while also being subsumed by such programmed mutator
processes.
Further research may show that such
systems involved in genetic repair might in fact function as coordinated, misrepair systems,
whose coordination through various levels of organization via forces, is enabled through
changes in force-fields, due to stress, across different levels of organization.
References
Burr, K., Palmer, H., and Roper, J. A.
Mitotic Non-Conformity in Aspergillus nidulans: The Effect of Reduced DNA Repair.
Heredity 27, 387
Burr, K. W., Roper, J. A., and Janice Relton.
(1982). Modification of chromosome instability in Aspergillus nidulans, Journal of
General Microbiology, 128: 2899-2907.
Lieber M. (1976a). The effects of temperature on genetic instability in
Aspergillus nidulans, Mutation Res. 34: 94-122.
Addendum IV
The original
data on which this article is based is presented in the author's Ph.D
thesis (Lieber, 1972). One can
download this thesis by accessing
http://ethos.bl.uk/Home.do
This is e-Thesis Online Service administered by the British Library.
Register on this site, and then in the site, type in the title of the thesis:
Environmental and Genetic Factors Affecting Instability at Mitosis in Aspergillus nidulans in order to initiate the download.
Once downloaded, begin reading
the thesis on page 214.
Addendum V
As documented, there is
much evidence for the existence and behavior of the dual mutator system
on the karyotypic level. Nevertheless, a person may wonder how one's
research peers viewed it. In 1976, the author received many requests for
reprints of his publications on the subject. In a personal communication
to the author, Barbara McClintock, the future Nobel Laureate, stated
that she recognized the importance of those investigations. This gives
the author's investigations a valid and credible place in the history of
biology.
Letter from Dr. Barbara McClintock

Addendum VI
My mentor, Professor Charlotte Auerbach,
advised me to submit my Ph.D. research initially to journals as a short
communication. She thought in that form my research results would be
accepted for publication. In fact, most helpfully, she composed the
short communication for me. It was very well written, due to her many
years of experience writing articles that were published. It was
submitted to a journal and was not accepted for publication. It was then
submitted to another journal, which also did not accept the article. The
reviewers for the journals indicated that a much more comprehensive and
detailed article should have been submitted. (My Ph.D. research was
later published in a more comprehensive form.) A transcription of
the short communication follows:
Environmental
and genetic factors affecting mitotic instability in Aspergillus
nidulans
Haploid strains of Aspergillus nidulans that carry a chromosome segment
in duplicate (one in normal position, one translocated to another
chromosome) are unstable at mitosis. Duplication strains have a
characteristic morphology, called "crinkled", and reduced linear growth
rate. They give frequent sectors of improved morphology and growth
rate, and these carry duplications of reduced sizes, due to
spontaneous deletions in one or other duplicate segment. In
suitably marked strains, position and extent of the deleted
portions can be determined. There has been convincing evidence that the
deletions are provoked by the presence of the duplications themselves
and that they never occur outside the duplicate segments except in
rare cases where they may overlap an adjoining chromosome region.
The origin of this instability is still obscure. At the moment, the
most promising type of hypothesis postulates that it is due to
perturbations of chromosome replication by the duplications. If
this is true, then a study of these instabilities is likely to help
elucidate the normal process of chromosome replication in eukaryotes.
The present communication summarizes a large number of data which show
(1) that temperature affects the instability of two different
duplications in opposite ways and (2) that, in strains carrying
both duplications, instability of one of them becomes subordinate to that of the
other. Although no explanation for either phenomenon can be
offered at this stage, the information may be useful for a future
comprehensive theory of duplication-induced errors in chromosome
replication.
(1)
Temperature dependence of Instabilities
Haploid colonies carrying duplications of a segment of either Chromosome
I (DpI) or of chromosome III (DpIII) were allowed to develop
individually in Petri dishes at different temperatures, and the
frequencies of improved sectors was scored. Table 1 shows the data
for the two extreme temperatures used. Those at intermediate
temperature fitted into trends observed, except for the finding that the
frequency of DpI sectors was even higher at 39.5 than at 42o
.
Table 1
Frequencies of improved sectors in two duplication strains grown at low
and high temperatures.
Temp.
DpI
DpIII
n
s
n
s
28o
40
1.4
40
7.0
42o
38
3.7
60
.86
n =
number of colonies examined; s = mean number of sectors per
colony.
In both
strains, the effect of temperature on sector frequency was significant
at the .01% level.
(2)
Interaction between duplications
Instability was studied in a haploid culture that carried both
duplications. It was found that deletions from the original DpIII
usually preceded those from DpI. As DpIII decreased in size
through successive deletions, this interaction became more pronounced,
as shown in Table 2.
Table 2
Interaction between DpI and DpIII
Strain
No of colonies examined Mean number of yellow
sectors* per colony
DpI
only, crinkled
40
1.1
DpI and DpIII,
highly crinkled 40
2.9
DpI, and a
greatly reduced DpIII; crinkled 61
13.7
*yellow
sectors are due to deletions in DpI.
It seems that DpIII acts as a pacemaker for DpI, and that this
interaction becomes more pronounced as the process of reduction of DpIII
proceeds. Again, this complex chromosomal interaction may be
a distorted reflection of interactions that go on during normal
chromosome replication and, because of this, may repay closer study.
References
I added the references and submitted the
article for publication.
|